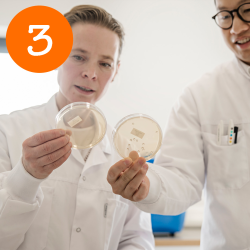

| 0 Produkte | - | CHF 0.00 |
| Zum Warenkorb | ||
Die Auswahl eines guten Nahrungsergänzungsmittels
Die Auswahl eines Bakterienstammes wird in erster Linie durch sein Potenzial bestimmt, dem Menschen einen gesundheitlichen Vorteil zu verleihen. Darüber hinaus müssen Nahrungsergänzungsmittel mit der körpereigenen Mikrobiota konkurrieren, um zu überleben, bis sie den Bereich des Verdauungstrakts erreicht haben, in dem sie ihre Wirkung entfalten können. Die Identifizierung und Empfehlung eines geeigneten Nahrungsergänzungsmittels ist somit ein sehr komplexer Prozess, bei dem viele Details zu berücksichtigen sind. Wie kann also ein geeigneter Kandidat ausgewählt und empfohlen werden? Die folgenden Referenzpunkte nach IPA* und ISAPP** können bei der Auswahl helfen:
Wissenschaftlich fundiert
Genau genommen sollten Nahrungsergänzungsmittel in kontrollierten Studien am Menschen positive Auswirkungen auf die Gesundheit nachweisen. Die Effekte einiger Bakterienstämme, wie z.B. L. reuteri DSM 17938, werden von mehreren hochwertigen Studien bestätigt, während die Datenlage zu anderen Bakterienstämmen dürftig ist. Hochwertige Studien, welche die Effekte spezifischer Stämme oder Stammkombinationen belegen, sind also essenziell und nicht wegzudenken.
Wirksame Dosierung und Qualität – mehr ist nicht unbedingt besser!
Wichtige Aspekte für die Qualität von Nahrungsergänzungsmitteln sind die Erhaltung der Lebensfähigkeit bis zum Ende der Haltbarkeit des Produkts, die Dosierung (durch koloniebildende Einheiten (KBE) angezeigt) und die Verwendung der korrekten Nomenklatur (Gattung, Art und spezifischer Stamm) aller im Produkt enthaltenen Organismen.
Die benötigte Dosis für Nahrungsergänzungsmittel variiert stark je nach Stamm und Produkt. Obwohl viele auf dem Markt erhältliche Nahrungsergänzungsmittel zwischen 1-10 Milliarden KBE pro Dosierung enthalten, wurde von einigen Produkten gezeigt, dass sie bei niedrigeren Dosierungen wirksam sind, während andere wesentlich höhere Dosierungen erfordern. Die Dosierung sollte daher der Konzentration entsprechen, welche in klinischen Studien verwendet wurde, um gesundheitliche Vorteile zu erzielen.
Beanspruchte Vorteile für bestimmte Stämme
Selbst wenn sie zur selben Gattung und Art gehören, können sich verschiedene Stämme durch einzigartige genetische und physiologische Eigenschaften unterscheiden. Zum Beispiel ist L. reuteri DSM 17938 eines der meist erforschten Bakterienstämme. Nachweislich hat es einen positiven Effekt auf mehrere gastrointestinale Beschwerden. L. reuteri ATCC PTA 6475, welches derselben Art angehört, scheint hingegen einen entzündungshemmenden Effekt zu haben, der sich auf die Knochengesundheit auswirkt.
Internationale Kultursammlung
Eine wichtige Voraussetzung für die Verwendung eines Nahrungsergänzungsmittels ist, dass der Bakterienstamm in einer international anerkannten Datenbank (Kultursammlung) registriert ist. Ein solcher Stamm ist beispielsweise der L. reuteri DSM 17938, der in der renommierten Deutschen Sammlung von Mikroorganismen und Zellkulturen (DSMZ) hinterlegt ist.
Lagerungsbedingungen
Einige Nahrungsergänzungsmittel müssen möglicherweise gekühlt werden, während andere den Vorteil haben, bei Raumtemperatur stabil zu sein.
Von einem seriösen Unternehmen hergestellt
Verantwortungsbewusste Nahrungsergänzungsmittelhersteller geben die Gattung, die Art und den Stamm des Bakteriums an und garantieren dessen Wirksamkeit bis zum Ende seiner Haltbarkeit.
Um weitere Informationen anfordern zu können oder Probleme im Zusammenhang mit dem Produkt zu melden, geben verantwortungsbewusste Hersteller ihre Kontaktdaten an.
* IPA (International Probiotics Association)
** ISAPP (International Scientific Association for Probiotics and Prebiotics)
AllergyCare AG
Vordergasse 43
CH-8200 Schaffhausen
-
Diese E-Mail-Adresse ist vor Spambots geschützt! Zur Anzeige muss JavaScript eingeschaltet sein!